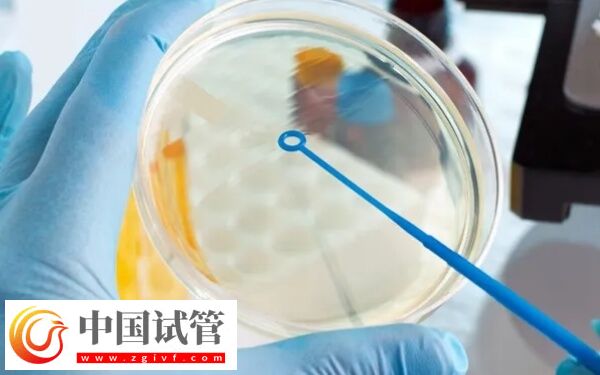
不能移鮮胚什么原因(圖1)

亚洲国产精品成人久久综合一区_国产日产精品一区_国产一区在线观看麻豆_亚洲精品久久久蜜桃
久久久亚洲高清|
亚洲自拍另类|
狠久久av成人天堂|
一区二区三区我不卡|
亚洲黄色在线视频|
一区二区三区成人精品|
午夜精品久久久久久久久久久久久|
欧美一区二区三区播放老司机|
久久精品国产在热久久|
欧美黑人一区二区三区|
欧美日韩亚洲不卡|
国产欧美日韩在线视频|
**性色生活片久久毛片|
夜夜嗨av一区二区三区中文字幕|
亚洲在线视频观看|
欧美日韩一区视频|
国产精品资源在线观看|
在线免费观看成人网|
一区二区三区国产|
久久精品视频免费播放|
欧美精品日本|
国产一区二区三区久久久久久久久
|
狠狠色丁香婷综合久久|
亚洲看片一区|
久久精品成人欧美大片古装|
欧美成人高清视频|
国产精品欧美日韩一区|
亚洲国产精品综合|
午夜影院日韩|
欧美精彩视频一区二区三区|
国产乱理伦片在线观看夜一区|
亚洲第一天堂av|
午夜在线电影亚洲一区|
欧美激情精品久久久久久蜜臀|
国产精品一区亚洲|
亚洲精品韩国|
久久久91精品国产|
国产精品福利在线观看网址|
亚洲国产毛片完整版
|
久久综合中文字幕|
欧美午夜精品一区|
极品少妇一区二区|
亚洲综合色婷婷|
欧美国产日产韩国视频|
国产女主播一区|
99视频在线精品国自产拍免费观看
|
99国产精品久久久久久久久久|
久久久久99|
国产精品日日做人人爱|
亚洲开发第一视频在线播放|
久久久久久久性|
国产精品一区二区久久国产|
亚洲最快最全在线视频|
巨乳诱惑日韩免费av|
国产一区二区三区的电影|
亚洲图片自拍偷拍|
欧美精品亚洲|
亚洲国产一区二区精品专区|
久久久久久69|
国产视频久久久久久久|
亚洲视频一二|
欧美绝品在线观看成人午夜影视|
在线不卡视频|
欧美在线视屏|
国产欧美一区二区三区久久人妖|
亚洲小说春色综合另类电影|
欧美日韩国产精品|
91久久久久久|
免费亚洲一区|
1000部精品久久久久久久久|
久久精品国产亚洲精品|
国产情侣久久|
午夜精品国产|
国产精品外国|
亚洲综合电影|
欧美性色aⅴ视频一区日韩精品|
亚洲免费观看在线观看|
欧美好吊妞视频|
亚洲精品四区|
欧美精品在线免费观看|
亚洲精品一区二区网址
|
国产日韩欧美高清|
欧美与黑人午夜性猛交久久久|
国产精品视频xxx|
亚洲欧美色婷婷|
国产美女在线精品免费观看|
午夜精品亚洲|
国产精品久久久久久亚洲毛片|
亚洲一区二区三区777|
国产精品成人免费|
亚洲欧美日韩在线观看a三区|
国产精品永久免费观看|
欧美中文在线观看|
在线欧美福利|
欧美激情精品久久久久久|
亚洲精品午夜精品|
欧美日韩国内|
亚洲小说欧美另类婷婷|
国产精品青草综合久久久久99|
午夜精品视频一区|
国产婷婷色一区二区三区在线|
久久精品99国产精品|
国内精品伊人久久久久av影院|
久久男人资源视频|
亚洲国产精品成人综合色在线婷婷|
欧美不卡一卡二卡免费版|
日韩午夜激情电影|
欧美性大战久久久久久久|
欧美亚洲一区二区三区|
韩日视频一区|
欧美成人激情视频|
一区二区三区不卡视频在线观看
|
欧美日本不卡视频|
亚洲图片欧美午夜|
国产偷国产偷精品高清尤物|
久久久久久久久久码影片|
亚洲人精品午夜在线观看|
欧美日韩在线不卡|
性欧美xxxx视频在线观看|
国内精品模特av私拍在线观看|
免费久久99精品国产自在现线|
9l视频自拍蝌蚪9l视频成人|
国产精品综合|
久久影视精品|
一本色道久久综合亚洲精品按摩|
国产日韩欧美视频在线|
欧美r片在线|
亚洲在线网站|
激情综合在线|
欧美日韩免费|
久久精品视频播放|
一区二区激情视频|
好吊日精品视频|
欧美日韩国产综合视频在线观看|
欧美一区国产在线|
亚洲激情精品|
国产精品自拍网站|
欧美成人一品|
午夜视频在线观看一区二区|
亚洲国产另类久久精品|
国产精品乱看|
麻豆久久婷婷|
亚洲欧美中文日韩v在线观看|
亚洲国产成人久久综合一区|
国产精品剧情在线亚洲|
牛牛影视久久网|
亚洲欧美一区二区三区久久|
亚洲国产导航|
国产亚洲精品久|
欧美日韩亚洲一区二区|
久久婷婷久久|
亚洲欧美日韩精品久久|
亚洲经典一区|
国产一区二区高清|
国产精品xxxxx|
欧美成人免费在线视频|
欧美一区午夜精品|
亚洲伦理在线免费看|
韩曰欧美视频免费观看|
国产精品久久综合|
欧美日本韩国一区|
久久久噜噜噜久久中文字幕色伊伊|
日韩视频免费看|
依依成人综合视频|
国产欧美日韩三区|
欧美日韩午夜剧场|
免费一级欧美片在线观看|
欧美在线啊v一区|
亚洲天堂偷拍|
亚洲精品久久久久久久久久久久|
国产一区二区久久精品|
国产精品成人免费精品自在线观看|
欧美国产精品一区|
玖玖精品视频|
久久久久久综合网天天|
亚洲欧美一区二区在线观看|
一本色道久久综合一区|
91久久精品网|
在线观看三级视频欧美|
国产一区二区三区最好精华液|
国产精品久久久久久模特|
欧美偷拍一区二区|
欧美乱人伦中文字幕在线|
免费亚洲电影|
免费观看一区|
蜜臀av性久久久久蜜臀aⅴ四虎|
欧美中文字幕第一页|
亚洲欧美在线aaa|
亚洲一区在线看|
亚洲亚洲精品三区日韩精品在线视频|
亚洲精品之草原avav久久|
亚洲黄色av|
亚洲高清成人|
亚洲高清av|
亚洲国产美女久久久久|
亚洲第一精品久久忘忧草社区|
国内精品国产成人|
国产主播一区|
黑人巨大精品欧美一区二区|
国产亚洲欧美一区在线观看|
国产亚洲欧美色|
国模私拍视频一区|
国产亚洲一区二区三区|
国产揄拍国内精品对白|